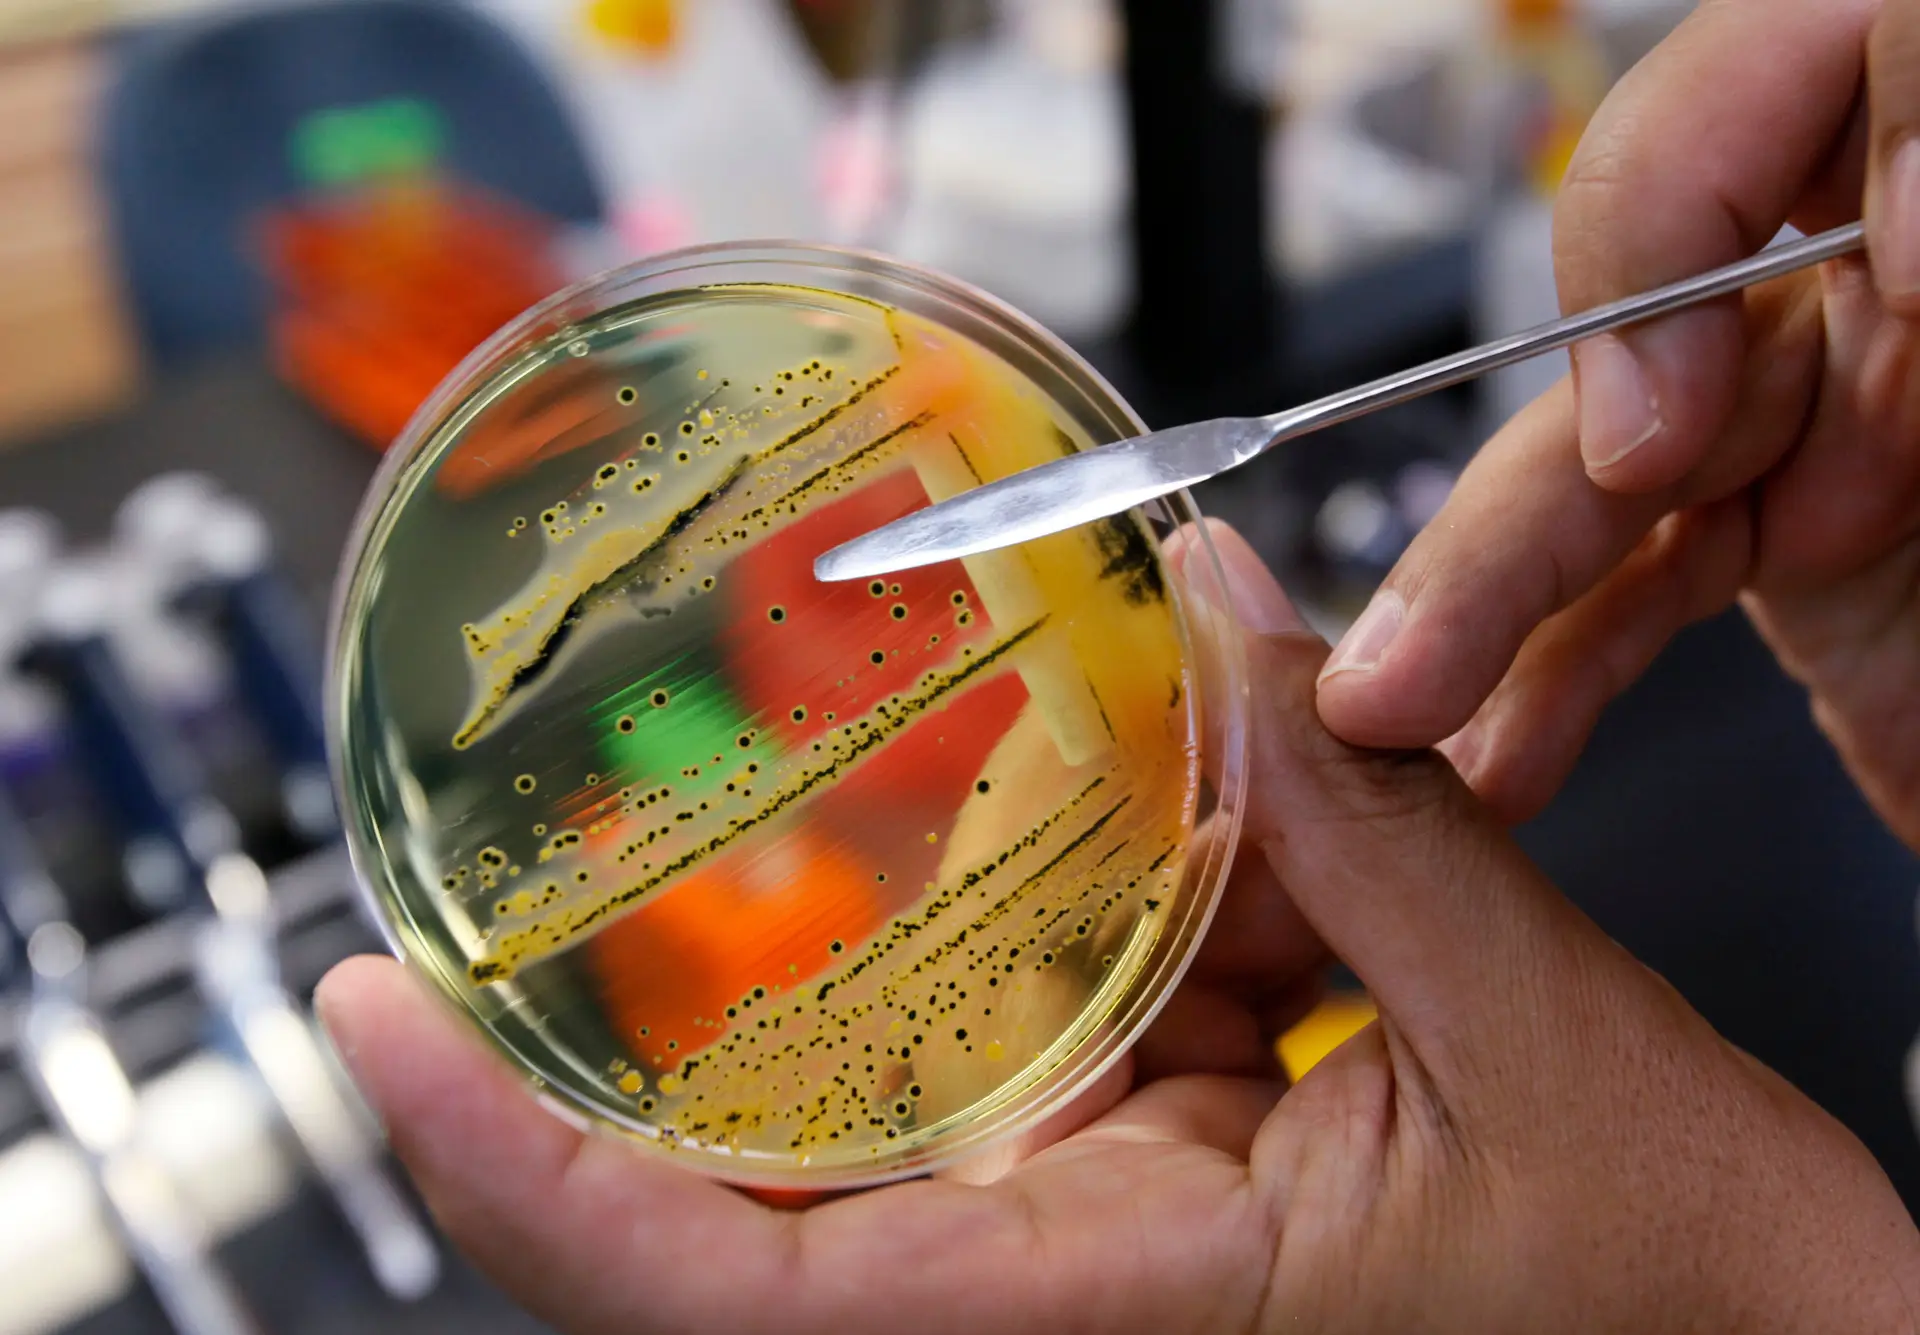
Salmonela examinada numa placa de petri em laboratório.

Cientistas dos EUA e do Canadá usaram inteligência artificial (IA) para descobrir um novo antibiótico que pode matar uma espécie mortal de superbactéria. É o exemplo mais recente de como as ferramentas da inteligência artificial podem ser uma força revolucionária na ciência e na medicina.
O alvo desta equipa internacional de cientistas foi Acinetobacter baumannii, uma bactéria hospitalar que sobrevive em superfícies e material médico em ambientes clínicos. Pode causar doenças como pneumonia, meningite e sépsis e é resistente a quase todos os antibióticos.
De acordo com a Organização Mundial da Saúde, A. baumannii é uma enorme ameaça para os doentes cujos cuidados requerem dispositivos como ventiladores, dada a sua resistência à maioria dos antibióticos existentes, e para a qual a OMS apela ao desenvolvimentos de novos tratamentos.
“Inimigo público n.º 1 das infeções bacterianas multirresistentes”
A equipa liderada por Jonathan Stokes, da Universidade McMaster no Canadá, aceitou o desafio para fazer frente à A. baumannii. “o que considero ser o inimigo público n.º 1 das infeções bacterianas multirresistentes”.
Desenvolver antibióticos é uma tarefa que exige muitos produtos químicos e muito tempo para os testar a todos. Normalmente, envolve testar centenas de milhares de produtos químicos para ver quais funcionam melhor contra a doença e "isso é extremamente trabalhoso, demorado e caro", diz o cientista Jonathan Stokes.
Foi neste momento do processo que Stokes e a restante equipa, que inclui cientistas do Instituto de Tecnologia de Massachusetts (MIT), recorreram à IA para obter ajuda.
A IA ajudou a reduzir as milhares de hipóteses de produtos químicos para um punhado que poderia ser testado em laboratório. O resultado foi um potente antibiótico experimental chamado abaucina, que ainda vai necessitar de mais testes antes de ser usado em seres humanos.
Stokes e a equipa publicaram a descoberta na revista Nature Chemical Biology
Treinar a Inteligência Artificial
Para encontrar um novo antibiótico, os investigadores tiveram de treinar a IA, alimentando-a com dados sobre produtos químicos que matam bactérias e estruturas químicas "associadas à atividade antibacteriana que queremos", explica Stokes.
“Testámos cerca de 7.500 produtos químicos, observando os que conseguiam inibir o crescimento da Acinetobacter baumannii e os que não conseguiam”.
Essa informação foi depois inserida na IA para que pudesse aprender as características químicas das drogas que poderiam atacar a bactéria problemática.
A IA testou então uma lista de 6.680 compostos cuja eficácia era desconhecida e assim poder prever quais desses produtos químicos “achava” que eram antibacterianos e aqueles que não eram.
Os resultados mostraram que a IA levou uma hora e meia para produzir uma lista restrita.
Os cientistas testaram 240 compostos em laboratório e encontraram nove antibióticos em potencial. Um deles foi o “incrivelmente potente” antibiótico abaucina. Experiências posteriores demonstraram que este antibiótico tratava feridas infetadas em ratinhos e foi capaz de matar a bactéria A. baumannii em amostras retiradas de pacientes infetados.
O próximo passo é aperfeiçoar o medicamento em laboratório e depois realizar testes clínicos.
“Estamos a entrar numa nova era com a Inteligência Artificial”
Os investigadores não têm dúvidas em afirmar que a IA tem o poder de acelerar a descoberta de novos medicamentos e promete acelerar drasticamente a pesquisa científica e a medicina. “Se nos ajudar a chegar a descobertas até 10% mais rápido, já é uma grande vitória para a sociedade”.
“O meu objetivo é descobrir novos antibióticos para salvar a vida das pessoas. Portanto, se existirem poderosos desenvolvimentos tecnológicos de Inteligência Artificial que me ajudem a atingir esse objetivo, vou adotá-los”, diz Jonathan Stokes.
Resistência de bactérias entre as 10 principais ameaças à saúde global
No final de 2022, a Organização Mundial da Saúde (OMS) considerou que a resistência bacteriana a antibióticos está entre as 10 principais ameaças à saúde pública global, salientando a sua "grande preocupação" com as infeções sanguíneas em contextos hospitalares.
No seu relatório sobre o sistema de vigilância, a OMS sublinhou que a medicina moderna depende de medicamentos antimicrobianos eficazes, mas alertou que foram registadas altas taxas de infeções resistentes em toda uma ampla gama de microrganismos nas várias regiões da OMS.
Infeções bacterianas foram uma das principais causas de morte em 2019
Uma em cada oito mortes registadas em 2019 está ligada a infeções bacterianas, que foram nesse ano a segunda causa de morte no mundo, revela um estudo divulgado na revista científica Lancet.
Naquele ano, 7,7 milhões de mortes (13,6% do total) estiveram relacionadas com 33 infeções bacterianas comuns, com mais da metade dos casos ligados a apenas cinco bactérias (S. aureus, E. coli, S. pneumoniae, K. pneumoniae e P. aeruginosa), mostra a investigação.
Os cálculos foram feitos "para todas as idades e sexos" em 204 países e territórios, tendo os investigadores usado 343 milhões de "registos individuais e isolados de patógenos para estimar as mortes associadas a cada patógeno e o tipo de infeção responsável".
De acordo com o trabalho, a S. aureus foi a principal causa bacteriana de morte em 135 países, seguida da E. coli (37 países), S. pneumoniae (24 países) e K. pneumoniae e Acinetobacter baumannii (4 países cada).
Os patógenos associados com a maioria das mortes também diferem consoante a idade.
O S. aureus foi associado à maioria das mortes em adultos com mais de 15 anos e a Salmonella enterica sorovar Typhi relacionada com a maioria das mortes em crianças de cinco aos 14 anos.
O patógeno associado ao maior número de óbitos neonatais foi o K. pneumoniae, enquanto o S. pneumoniae foi o mais mortal em crianças com menos de cinco anos de idade, com exceção das recém-nascidas, mostrou o estudo.